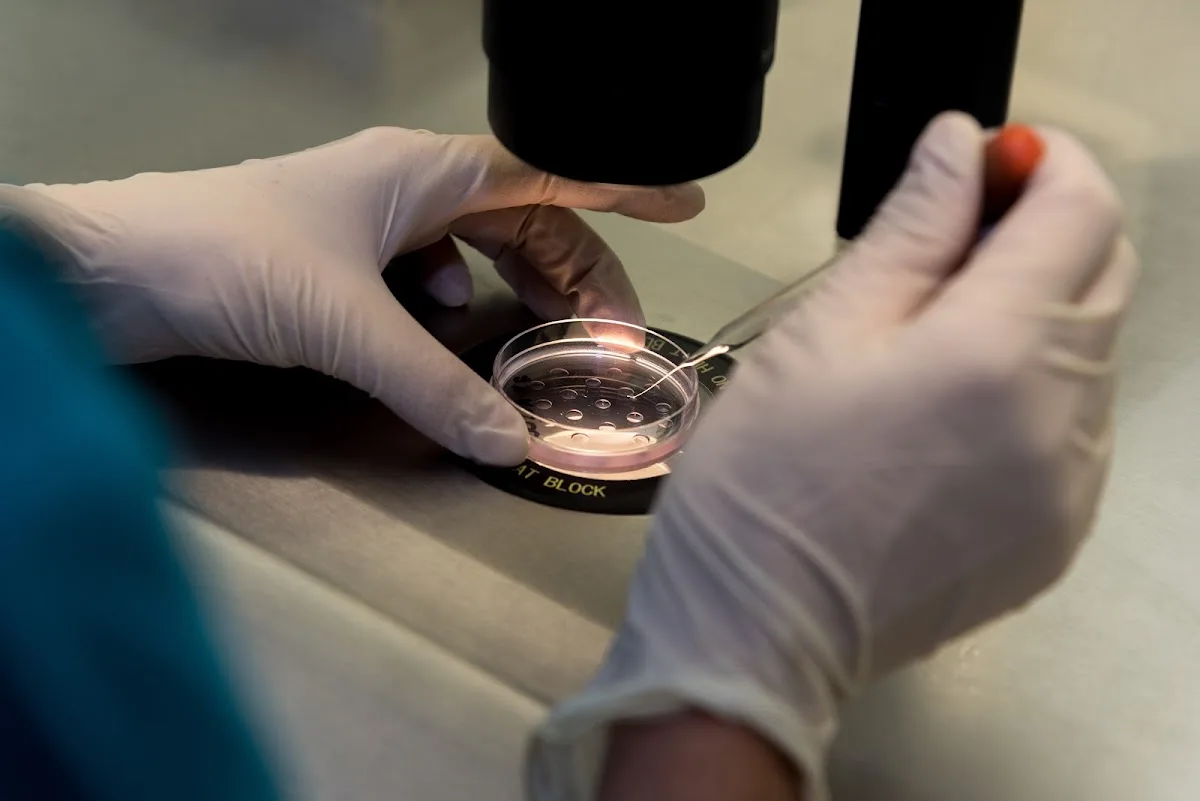
Genesis Fertility Clinic

Best IVF and Fertility Clinics in Cyprus
Clinics with the highest ratings and verified quality care in this region.
Top IVF Clinics in Cyprus
Clinics with the highest ratings and verified quality care in this region.

Embryon Fertility Center | IVF Clinic Cyprus
Embryon Fertility Center, located in Limassol, Cyprus, is a renowned IVF clinic dedicated to helping…

Cyprus Hope Fertility Team Z
Cyprus Hope IVF offers a comprehensive range of fertility treatments in a welcoming and professional…

Team Miracle - Cyprus IVF Centre
Cyprus IVF Centre, operated by the renowned Team Miracle, is a leading facility in Cyprus…

Pedieos IVF Center
Pedieos IVF Center, located in Nicosia, Cyprus, is a leading facility specializing in fertility treatments…

Nicosia IVF - Sevinc Hospital
The Lefkoşa IVF Center, led by Dr. Mehmet Emin Kaptan, offers a comprehensive range of…

EuroCARE IVF Center
EuroCARE IVF is a fertility clinic located in North Cyprus (Ranya), specializing in comprehensive assisted‑reproduction…

Embryorigin
Embryorigin Fertility Centre is a comprehensive fertility clinic located in Cyprus, specializing in assisted reproductive…

British IVF Hospital
British Cyprus IVF (British Kıbrıs Tüp Bebek Hastanesi) is a leading fertility clinic located in…

Dunya IVF Center
Dünya Tüp Bebek Merkezi, Kıbrıs'ta ailelerin hayallerini gerçeğe dönüştürmek için yüksek başarı oranları ve %98…
Genesis Fertility Clinic
Genesis Fertility Centre is a fertility clinic located in an undisclosed location, specializing in comprehensive…

Cyprus Miracle IVF by Dr. Firdevs
Miracle IVF Cyprus is a premier fertility clinic that specializes in personalized IVF treatments with…

Gaia Fertility
Popular Destinations in Cyprus
Explore popular cities and regions in Cyprus.
Frequently Asked Questions
Common questions about IVF in Cyprus.